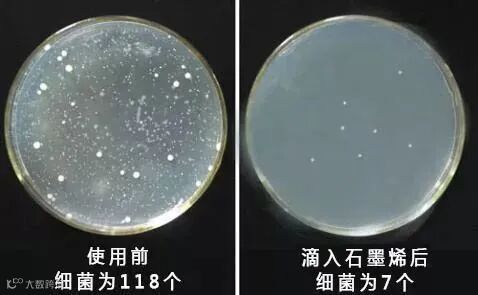

很多男性在对待换内裤这件事上比较懒









































 军武优选
军武优选
很多男性在对待换内裤这件事上比较懒